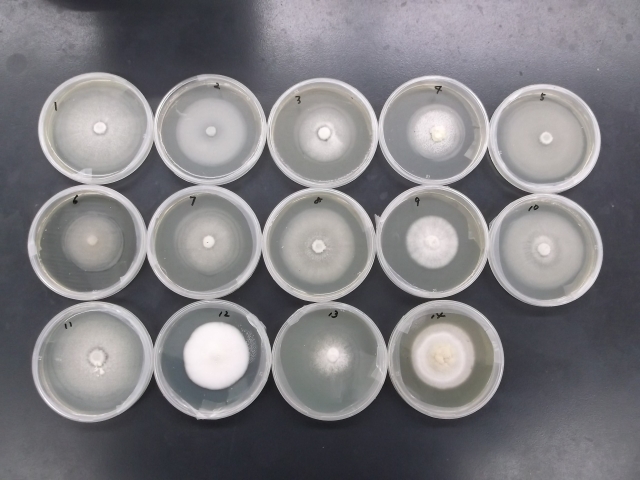

ハナビラタケ優良系統の選抜と安定生産技術の開発
林業研究所 西井孝文
1.はじめに
ハナビラタケは、ハナビラタケ科ハナビラタケ属のきのこで、初夏から秋にかけてマツなどの根元や切り株に発生します(図-1)。風味、歯切れが良く生産量が少ないことから、貴重なきのことして高値で取り引きされていますが、他の栽培きのこに比べて菌糸の伸びが遅いため雑菌に汚染されやすく、また、発生管理が難しいことから生産者への導入が進まない状況にあります。そこで、ハナビラタケの安定生産に向けて空調栽培に適した優良系統の選抜を行いました。

図-1.ハナビラタケ野生株
2.菌株の収集と菌糸伸長状況の調査
県内外のきのこ関係者等を通じて、ハナビラタケの菌株の収集を行ったところ、野生、栽培系統を含め20系統を超える菌株が集まりました。
そこで、収集した主な菌株についてPDA平板培地を用いて菌糸の伸長状況を調査し(図-2)、菌糸伸長が良好かつ培養中に原基形成の見られる菌株を選抜しました。
図-2. PDA平板培地における菌糸伸長状況
3.培地基材の検討
スギオガ粉、広葉樹オガ粉、カラマツオガ粉、バーク堆肥と米ぬかをそれぞれ容積比で4:1の割合で混合し、含水率を63%前後に調整しました。これらの培地を直径32㎜の試験管に50g、高さが約150㎜になるよう均一に詰め、118℃で30分間殺菌しました。一晩放冷した後、ハナビラタケ菌糸体を接種し、温度24℃、湿度70%の条件下で培養しました。接種3日後から75日間の菌糸伸長量を調査したところ(図-3)、カラマツオガ粉における菌糸伸長量が他の培地基材に比べて有意に大きく、ハナビラタケの菌床栽培にはカラマツオガ粉が有効であることが分かりました。

図-3.培地の種類別菌糸伸長状況
4.栄養体の添加割合の検討
カラマツオガ粉とフスマを容積比で3:1、4:1、5:1、6:1の割合で混合し含水率を63%前後に調整した後、先の試験と同様の方法で試験管に詰め、118℃で30分間殺菌しました。これにハナビラタケ菌糸体を接種し、温度24℃、湿度70%の条件下で培養しました。接種3日後から108日間の菌糸伸長量は表-1のとおりで、5:1、6:1の混合割合で菌糸伸長量は有意に大きくなりましたが、6:1の混合割合では菌糸の密度が薄くなりました。このことから、菌床培地におけるフスマの添加割合は、容積比でオガ粉の20%程度が適していると考えられました。
表ー1.フスマ添加割合別の菌糸伸長量

5.菌床袋栽培による優良系統の選抜
PDA平板培地において、培養中に原基形成の認められた津27、津28、奈良NSC-2、林研A株および栽培品種を用いて菌床袋栽培を行いました。
2.0㎏菌床1個当たり、カラマツオガ粉4.0ℓ、フスマ150g、ビール粕100gの割合で混合し、含水率を68%前後に調整し袋に詰めました。118℃で90分間殺菌した後あらかじめ同様の培地組成で培養した種菌をそれぞれ接種し、温度22℃、湿度70%の条件下で培養しました。培養中ある程度原基形成が進んだ時点で菌床の袋の上部を切り取り、温度18℃、湿度95%の条件下で子実体の生育を促しました。
発生試験に用いた菌株すべてから子実体が発生し、特に奈良NSC-2、林研A株において栽培品種と同様1菌床当たり300gを超える発生が認められ、優良系統として選抜しました(図-4)。

図-4. ハナビラタケ林研A株の発生状況
6.選抜株を用いた発生条件の検討
先と同様の条件で作製した2.0㎏菌床に林研A株を接種し、20℃および22℃、湿度はいずれも70%の条件下において50日間および60日間培養しました。培養完了後菌床の袋の上部を切り取り、温度18℃、湿度95%の条件下で子実体の生育を促しました。
各培養条件における発生量は表-2のとおりで、いずれの培養条件においても1菌床当たり300gを超える発生が認められ、発生量に有意差は認められませんでした。
このことから、ハナビラタケ菌床袋栽培においては、培養条件の幅が比較的広く、他のきのこ栽培施設の流用が可能であることが示唆されました。
表ー2.培養条件別の子実体発生量

7.生産者施設を利用した実証試験
ハナビラタケの栽培条件は、ハタケシメジ栽培と類似することから、県内のハタケシメジ生産者施設を利用した栽培試験を行いました。
林業研究所において2.0㎏菌床を作製し、ハナビラタケ林研A株を接種しました。温度22℃、湿度70%の条件下で菌糸の活着を促した後、県内のハタケシメジ生産者施設2カ所に菌床を移動し、追培養を行いました。
袋内で原基形成が進んだ時点で、袋の上部を切り取り、温度18℃、湿度95%前後の発生室で子実体の生育を促したところ、いずれの施設においても1菌床当たり300gを超える発生が認められ(図-5)、導入可能なことが明らかになりました。

図-5. 生産者施設における発生状況
8.おわりに
ハナビラタケは、まだ流通量が少なく入手が困難ですが、コリコリした独特の食感と、免疫活性を高めると言われているβ-グルカンの含有量が極めて高いきのことして注目されています。今後は、機能性を高めた栽培方法の開発及び、生産現場における実証試験を行い、生産量の拡大を図っていきたいと考えています。